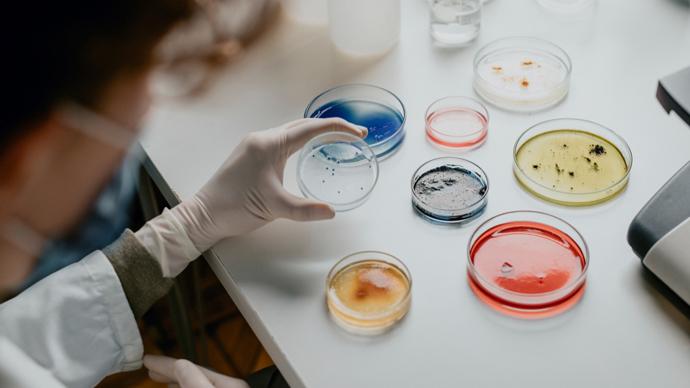

從隱身夥伴到抗癌新藥,“細菌療法”走向臨牀

圖/視覺中國
在微觀世界的隱祕角落裏,一個典型細菌的直徑僅約1微米,相當於人類頭髮絲粗細的百分之一。然而,這些看似微小的生命形式,卻擁有驚人的適應能力和生存智慧——它們無處不在,就連人體也是它們繁衍生息的場所。
在人類文明的歷史長河中,包括細菌在內的微生物羣落,一直與我們進行着無聲的對話,除了發酵與瘟疫,它們還在悄無聲息地影響着人類健康。
早在1700多年前,我國東晉名醫葛洪在《肘後備急方》中“以糞清治療食物中毒和嚴重腹瀉”的記載,就是人類利用人體腸道共生微生物治療疾病的樸素實踐。2023年,全球首款基於糞菌移植原理、用於治療複發性艱難梭菌感染的口服糞便微生物藥物VOWST(SER-109)獲批上市。
從傳統醫學的經驗性探索到現代精準醫療的機制性突破,這一相隔千年的時空鏈接,展現了人類對生命奧祕認知的螺旋式上升。
隱身小夥伴,從“看不見”到“被看見”
早在公元前36年,羅馬政治家馬庫斯·瓦羅就在其著作《論農業》中提出了類似“細菌”的概念:環境中存在着肉眼看不見的微小活物,它們悄無聲息地通過口鼻進入人體,引發嚴重疾病。這樣的觀點在當時顯得驚世駭俗,因爲絕大多數人相信疾病是由超自然力量或瘴氣等原因所致。
直到17世紀,人們才通過嚴謹的實驗觀察,證實微生物的存在。1665年,英國科學家羅伯特·胡克首次使用顯微鏡發現了真核細胞結構,隨後在《顯微圖志》中首次使用了“細胞”一詞。與胡克同時期的荷蘭人安東尼·列文虎克,則首次觀察到了水滴中的細菌和原生動物等微生物,徹底顛覆了人們對生命世界的傳統認知。不僅如此,他還第一次在人體口腔碎屑中發現了大量共生微生物。
雖然早在數千年前人類就掌握了釀酒、釀醋的技藝,但古人對發酵原理並不瞭解。直到19世紀中葉,法國科學巨匠路易斯·巴斯德提出,發酵的本質是微生物在進行代謝活動。1857年,他發表經典論文《關於乳酸發酵的記錄》,並通過一系列實驗證明不同微生物的代謝活動決定了發酵產物的性質——酵母菌產生酒精,乳酸菌生成乳酸,而腐敗菌則分解有機物產生臭味物質。
而美國古生物學家與解剖學家約瑟夫·萊迪在解剖動物腸道時,首次系統記錄了動物體內的微生物羣落,爲人類以後提出“微生物組”這一概念埋下伏筆。
又過了半個世紀,1907年,俄國免疫學家與微生物學家伊拉·梅契尼科夫從保加利亞農民的長壽現象中發現,酸奶中的乳酸菌能抑制腸道腐敗菌生長,由此提出“衰老源於自身中毒”的理論,開創了益生菌研究的先河。
1917年,德國醫學微生物學家阿爾弗雷德·尼塞爾在歐洲戰場上救治痢疾病人時,從一名士兵的健康糞便中分離出一株被命名爲“Nissle 1917”的益生菌,在那個抗生素尚未問世的時代,它成爲治療腸道感染的天然武器。
這些突破性發現本應推動微生物組研究進入快車道,卻被19世紀末至20世紀初橫行的流感、霍亂、結核病等傳染病耽誤——當醫生和科學家忙着用抗生素對抗致病“壞細菌”時,誰會關注腸道里那些看不見的“好細菌”呢?
重塑認知邊界,揭祕人體“第二基因組”
1953年, DNA雙螺旋結構的發現推動了生命科學各領域的範式變革。DNA序列分析技術的興起,爲微生物分類學提供了分子水平的精準標尺,開啓了基於遺傳信息的微生物系統發育研究新紀元。
上世紀60年代末,美國微生物學家卡爾·烏斯首次構建了涵蓋細菌、古菌和真核生物的三域生命樹。他的工作不僅確立了古菌作爲獨立生命域的地位,還發展起一系列方法爲微生物學提供了標準化、可量化的分類工具,使科學家能夠準確識別不同生態環境中的未知微生物。
又過了約20年,DNA測序技術的進步推動了微生物研究從“物種鑑定”向“羣落解析”的跨越。美國科學家諾曼·佩斯開創性地提出可直接提取環境樣本(如土壤、水體、人體腸道)中的總DNA(即宏基因組),並分析出微生物羣落的結構組成。這一方法首次揭示了自然界中大量“不可培養微生物”的存在。1985年,佩斯團隊利用該技術分析美國黃石公園熱泉微生物羣落,首次證實極端環境中微生物多樣性的豐富程度遠超預期。

圖/視覺中國
這些奠基性的研究突破直接催生了後續的人類微生物組計劃、地球微生物組計劃等國際大科學項目。從單一微生物的“身份識別”到整個微生物組的“結構解碼”,兩位先驅的工作徹底重塑了人類對生命微觀世界的認知邊界。
隨着基因組時代到來,科學家發現,人體內共生微生物的基因總量是人類基因組的上百倍,其功能與影響卻被長期忽視。爲填補這一認知空白,2007年美國國立衛生研究院啓動了人類微生物組計劃,以揭示我們的“第二基因組”對人類生理與病理的深遠影響。
該計劃整合了微生物學、宏基因組學、代謝組學、轉錄組學、生物信息學、臨牀醫學等不同領域的技術與理論,推動研究從“描述性”向“關聯性”跨越。它首次揭示健康人體微生物組的複雜性,進一步顛覆了“微生物僅是病原體”的傳統觀念,並揭示出微生物組失衡與疾病進展存在直接關聯,更爲開發基於微生物組的精準醫療策略奠定了科學基礎,如益生菌療法、糞便移植技術等。
例如,該計劃發現早產孕婦陰道內乳酸菌減少、感染相關性細菌增多,且這些微生物組成的變化與維生素D缺乏相關;炎症性腸病患者腸道中兼性厭氧菌增加、專性厭氧菌減少,且這些變化與微生物代謝活動及宿主免疫反應相關。
人菌共生,攜手維護免疫屏障
本世紀初,科學家在探索共生微生物對機體代謝影響的同時,也開始關注共生微生物與宿主免疫系統的相互作用。
20世紀中葉,現代人體微生物組研究迎來了兩項關鍵技術突破——厭氧微生物培養技術和無菌動物模型技術,這爲後續機理探索奠定了堅實基礎。美國生物學家傑弗裏·戈登實驗室以此爲基礎,率先將微生物組高通量測序、厭氧微生物培養及無菌動物模型三大技術深度整合,開創了微生物組研究新範式。
戈登實驗室的一系列研究揭示了腸道共生微生物與人體代謝的深層關聯。例如,在肥胖研究中,他們通過高通量測序發現肥胖人羣腸道菌羣存在特徵性改變,當將肥胖患者的糞便菌羣移植給無菌小鼠後,小鼠的脂肪積累速度也會加快,由此證明腸道微生物可直接調控宿主的能量吸收。
針對兒童營養不良,戈登實驗室將一些營養不良兒童的糞便移植到無菌小鼠體內,這些小鼠也隨之發生體重增加減緩,骨骼發育不良及多種代謝、免疫異常症狀。這些突破性發現構建了“菌羣-代謝-疾病”的完整鏈條,爲後續開發更有效的營養干預策略提供了理論支撐。
2009年,美國免疫學家丹·利特曼實驗室發現,一種名爲分節絲狀菌的腸道革蘭氏陽性細菌能夠誘導產生一羣具有增強炎症反應功能的特殊輔助性T細胞,即Th17細胞。隨後,日本科學家本田賢也的實驗室也很快報道,腸道共生梭菌可誘導產生一羣具有免疫抑制功能的特殊調節性T細胞,即Treg細胞。

圖/Pixabay
這兩個實驗室的開創性工作表明,不同種屬的共生微生物對機體腸道黏膜免疫系統具有正負兩方面的調控作用,從而維持腸道黏膜免疫應答反應的陰陽平衡。
那麼,腸道內的共生微生物究竟是如何調控我們的免疫系統的呢?早在20世紀70年代,美國微生物學家及免疫學家丹尼斯·卡斯帕在研究細菌感染的過程中意識到,共生微生物可能參與了感染進程。在人類腸道中定殖的數百種共生微生物中,對青黴素有耐藥性的脆弱擬桿菌是從感染部位分離出的最常見的微生物。他的實驗室首次報道,這種共生菌表面的八種莢膜多糖可能賦予其獨特的免疫原性,從而影響機體健康。
經過長達近30年的研究,卡斯帕實驗室於2008年最終證明,來自脆弱擬桿菌的莢膜多糖A是介導其免疫調節功能的主要分子。這一發現爲理解共生微生物如何通過具體活性分子來調節機體免疫力提供了重要實驗證據,開啓了共生微生物與機體免疫力因果關係分子機理研究的新篇章。
新技術孕育變革,下一代益生菌已在路上
從顯微鏡的發明到基因測序技術的發展,從無菌動物的創建到厭氧微生物遺傳操作技術的成熟,人類微生物組研究的每一次突破都伴隨着技術革新,新型研究方法已在悄悄醞釀人體共生微生物組研究的下一輪變革。
2023年,我國牽頭啓動了全球“未培養微生物培養組”計劃。儘管目前我們對人體內共生微生物羣落有了較爲全面的瞭解,但仍有大量微生物因生長條件極爲特殊而難以在實驗室條件下進行培養。該研究計劃旨在通過開發新的培養技術和方法,對那些尚未培養的微生物進行分離、培養和功能鑑定。
這些未培養微生物可能蘊藏着獨特的代謝功能和生物學特性,對人體健康和疾病的發生發展或許有着不可忽視的影響。通過未培養組計劃的實施,我們有望發現新的微生物種類和功能基因,進一步豐富和完善人體共生微生物組圖譜,爲深入探究微生物與人體之間的相互作用提供更全面、準確的信息。
隨着基因編輯技術的持續進步,如何實現針對不同門類共生微生物的基因編輯正成爲當下研究熱點。未來,可通過對人體微生物組的深度改造與精準操控,來增強人體健康。比如,我們可通過設計改造共生微生物的基因元件,使其產生更多對人體有益的代謝產物,幫助人體更好抵禦疾病。
同時,針對益生菌開展基因編輯也大有可爲。通過編輯益生菌基因,可提升其在人體內的定殖能力及合成有益代謝產物的能力,讓它們更長久有效地發揮作用。此外,相關技術也將爲開發新型微生物療法開闢新路徑,未來有望在治療免疫或代謝疾病等多種複雜病症中取得關鍵突破。
在生命科學蓬勃發展的當下,人工智能技術憑藉卓越的數據處理與分析能力,已然成爲推動該領域前進的關鍵力量。人體微生物組研究每天都會產生海量數據,人工智能技術就像一個超級偵探,能從紛繁複雜的數據中找出微生物組與人體健康、疾病之間的潛在關聯和內在規律。通過建立精準的預測模型,人工智能可根據微生物組的結構和代謝特徵,提前預測疾病發生的風險、發展的進程,以及對治療的反應,爲制定個性化醫療方案提供有力依據。
不僅如此,人工智能算法還能挖掘未知的微生物基因功能元件,鑑定潛在微生物代謝途徑及其產物,爲科研人員設計新型微生物療法和藥物提供思路,加速基礎研究成果從實驗室到臨牀的轉化應用。
(作者爲中國科學院分子細胞科學卓越創新中心研究員)

















